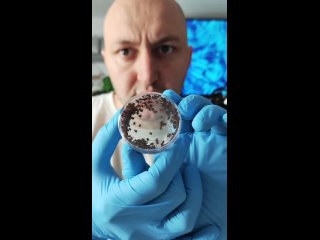

Введение фруктов в рацион коров может разнообразить питание и способствовать улучшению их пищевого поведения, однако важно учитывать индивидуальные особенности пищеварения животных. Использование свежих фруктов как лакомства помогает повысить благополучие и снизить стресс у сельскохозяйственных животных.

Валерий Шишкин
И молоко сливочное дают.
Роман Бресталио
Анна Калинкина
Сашенька Хочулета
Ilya Kozlov
Анна Калинкина
Анна Калинкина
Аннушка Амбарцумова
Надежда Ляликова
Михаил Харитонкин
Алексей Караулов
Олег Патраков
Дина Зильберман
Наталья Капустеря
Александр Балабанов
Павел Фадеев
Виктория Проценко
Павел Фадеев
Ольга Кетлер
Роман Богданов
Ольга Кетлер